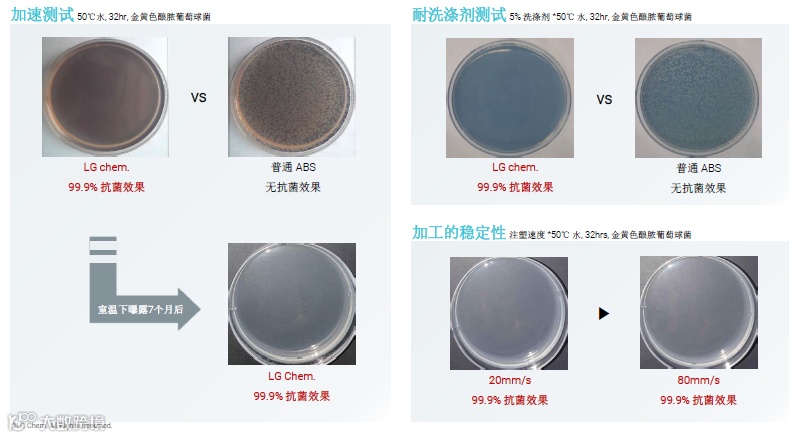

1
关键性能
抗细菌 & 抗真菌 ABS
- 长期抗细菌达到99.9%
- 已取得韩国国内及国际抗菌相关认证


2
目前使用产品
正在使用的产品 - 冰箱门把手
正在开发中 - 医疗显示器白色外壳
空气净化器顶盖


3
特点
1、长期抗细菌性能
通过加速测试证实了可达到99.9% 抗细菌效果
通过在室温下,7个月的曝露,证实了可达到99.9%的抗细菌效果
通过在5%浓度的洗涤剂下,证实了可达到99.9%的抗细菌效果
抗细菌效果效果与产品的注塑速度无关
(洗涤剂及加工工艺的稳定性条件下,能保持较好的抗细菌性能)
2、抗真菌性能

(抗真菌性能能够达到 0 级ASTM G21 认证,并证实了真菌无法在LG化学的抗菌ABS表面存活。)
3、颜色稳定性
白色配色效果

(现有的抗菌材料由于抗菌剂的颜色,材料颜色偏红。 相反,LG化学的抗菌ABS材料能够提供与普通ABS相同的白度,因此可更广泛的应用于各类产品。)
LG化学抗菌ABS在高温高湿下的
颜色稳定性

(在高温高湿条件下长期曝露后,LG化学的抗菌ABS能够保持较小的颜色变色)
4
相关认证
LG化学的抗菌ABS取得了全球权威机构的认证

5
市场趋势
因为covid-19,消费者对细菌的控制意识在提升。在这样的趋势下,在日常生活中,消费者更愿意购买能抗菌的产品。



6
应用
应用场景广泛适用于:家电电器、医疗设备、移动设备等。
广州珍顺作为LG化学一级代理商,可为客户提供方便快捷的抗菌ABS供货服务,有需要的伙伴赶紧拨打020-3203 9131与我们联系吧!




